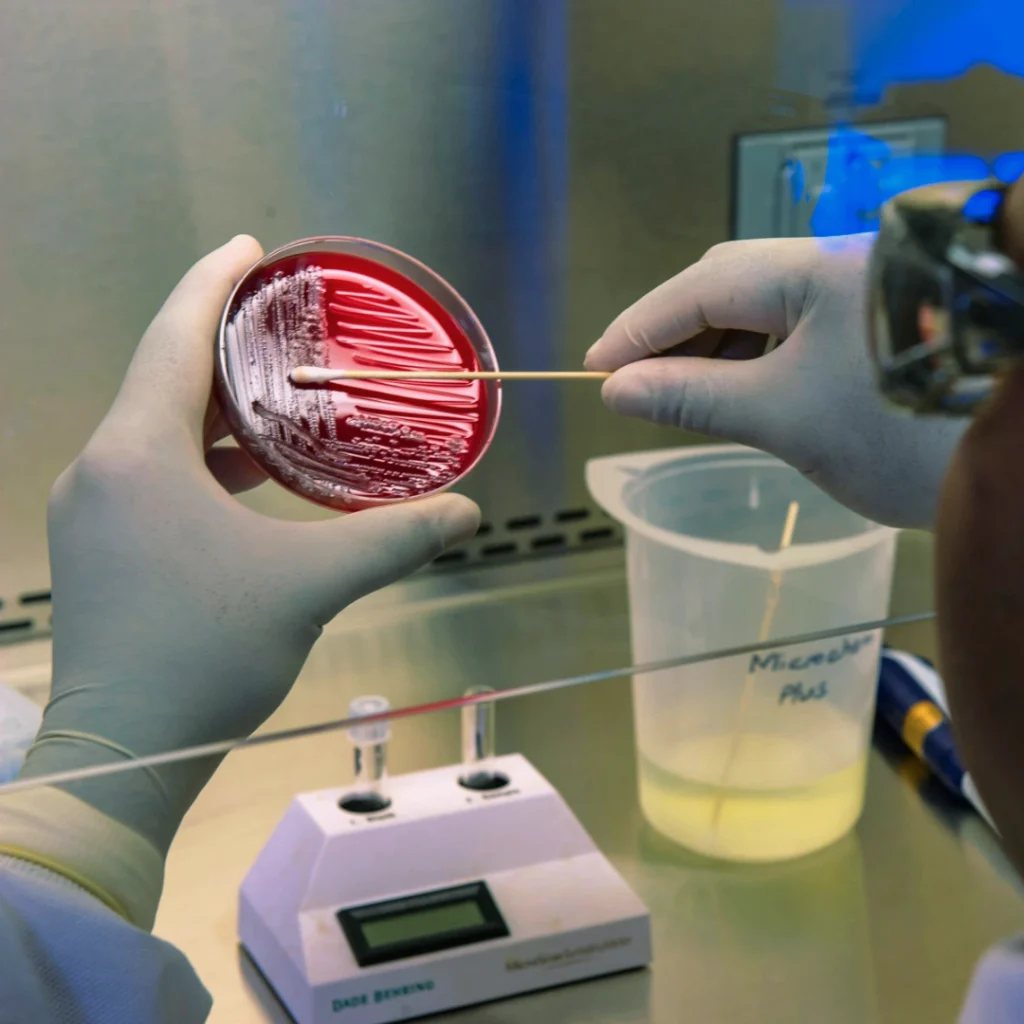
A petri dish of bacteria is it harmful to your health?

Is It Unhealthy to Have Rugs and Carpets in the House?
Rugs and carpets have been a staple of home décor for centuries, adding warmth, comfort, and style to living spaces. However, their potential impact on health has sparked debate among home-owners, interior designers, and health professionals alike. In this article, we will explore whether having rugs and carpets in the house is truly unhealthy, examining both the benefits and potential risks associated with them. By understanding their effects, you can make informed choices to ensure your home remains a healthy and welcoming environment.
1. The Appeal of Rugs and Carpets in Homes
Rugs and carpets are more than just decorative features; they serve practical purposes in homes. Here’s why many homeowners choose to have them:
- Comfort and Warmth: Carpets provide a cushioned surface underfoot, making them ideal for cold climates or tiled floors.
- Sound Insulation: They help reduce noise levels, particularly in multi-storey homes, by absorbing sound.
- Aesthetic Value: Available in a wide range of colours, patterns, and materials, rugs and carpets can elevate the style of any room.
- Safety: Rugs and carpets can minimise the risk of slips and falls, particularly for children and elderly individuals.
While these benefits are significant, questions surrounding their health implications must also be addressed.
2. Potential Health Risks of Rugs and Carpets
Although rugs and carpets have numerous advantages, their impact on indoor air quality and health cannot be overlooked. Below are the key concerns:
a. Accumulation of Allergens
Rugs and carpets act like sponges, trapping allergens such as dust mites, pet dander, and pollen. For individuals prone to allergies or asthma, this accumulation can trigger symptoms like sneezing, coughing, and respiratory discomfort.
b. Retention of Moisture and Mould
Spills, high humidity, or inadequate cleaning can lead to moisture retention in carpets, creating an environment for mould and mildew growth. These fungi can release spores into the air, potentially causing respiratory issues or aggravating pre-existing conditions.
c. Harbouring Bacteria
Research indicates that carpets can harbour bacteria such as E. coli and Salmonella, especially in high-traffic areas or if food particles are dropped and not cleaned promptly.
d. Release of Volatile Organic Compounds (VOCs)
New carpets, particularly those made from synthetic materials, can emit VOCs such as formaldehyde or benzene. These chemicals, often found in adhesives or dyes, can contribute to indoor air pollution and cause headaches, dizziness, or irritation of the eyes and throat.
e. Trapping Fine Dust Particles
Fine particles, including household dust and pollutants, settle into the fibres of carpets and rugs. Without proper cleaning, these particles can resurface, affecting air quality and posing risks to people with respiratory conditions.
3. Rugs and Carpets vs. Hard Flooring: Health Perspectives
When considering whether rugs and carpets are unhealthy, it is helpful to compare them to alternative flooring options like hardwood, tile, or laminate. Here are the key differences:
- Hard Flooring: Easier to clean and less likely to trap allergens or moisture, making it a better choice for allergy sufferers.
- Rugs and Carpets: Provide better insulation and comfort, but require regular maintenance to mitigate health risks.
Ultimately, the decision between the two depends on personal preferences, household composition, and the time you’re willing to invest in upkeep.
4. Mitigating the Risks: How to Maintain Healthy Rugs and Carpets
The potential health concerns of rugs and carpets do not mean they should be avoided entirely. By adopting good cleaning and maintenance practices, you can enjoy their benefits while minimising risks.
a. Vacuum Regularly
Use a vacuum cleaner with a HEPA filter to remove dust, allergens, and fine particles. Aim to vacuum at least twice a week in high-traffic areas and once a week elsewhere.
b. Invest in Professional Cleaning
Deep-cleaning carpets at least once a year can eliminate deeply embedded dirt, bacteria, and allergens. Steam cleaning is particularly effective as it kills dust mites and removes moisture.
c. Use High-Quality Mats
Place doormats at entrances to trap dirt and debris before they reach your carpets. Encourage family members and guests to remove shoes when entering the house.
d. Control Humidity Levels
Maintain indoor humidity levels between 30-50% to prevent mould growth. Consider using a dehumidifier if necessary.
e. Address Spills Promptly
Clean up spills immediately to prevent moisture from seeping into the carpet fibres. Use cleaning solutions appropriate for your carpet material to avoid staining.
f. Choose Low-VOC Carpets
If purchasing a new carpet, look for those labelled as low-VOC or certified by environmental organisations like Green Label Plus. Ventilate the room after installation to reduce VOC emissions.
5. Health Benefits of Rugs and Carpets
Interestingly, rugs and carpets can also offer health benefits when managed correctly:
a. Improved Indoor Comfort
Soft surfaces like carpets reduce stress on joints, particularly beneficial for older adults or people with chronic pain.
b. Thermal Insulation
Rugs and carpets help maintain room temperature by acting as insulators, reducing energy consumption and the risk of cold-related health issues.
c. Noise Reduction
Minimising ambient noise levels can create a calmer, more peaceful living environment, potentially reducing stress and improving mental health.
d. Safety Enhancements
For households with children or elderly residents, carpets can cushion falls, preventing injuries.
6. Special Considerations for Allergy and Asthma Sufferers
For those with allergies or asthma, carpets may seem like a poor choice. However, adopting specific strategies can allow these individuals to safely enjoy the benefits of rugs and carpets:

- Opt for low-pile carpets that trap fewer allergens. A flatwoven rug with a rubber underlay would be a good choice. Adding rubber underlay to a flatwoven printed rug will give additional cushioning.
- Use hypo-allergenic area rugs that are easier to clean and replace.
- Vacuum with a certified asthma-friendly vacuum cleaner.
- Wash rugs frequently, particularly those in bedrooms and living rooms.
7. Environmental and Sustainability Concerns
Beyond health, the environmental impact of rugs and carpets is another factor to consider. Many synthetic carpets are made from petroleum-based materials, which contribute to carbon emissions. However, eco-friendly options such as wool, jute, or sisal rugs are biodegradable and offer a sustainable alternative.
Additionally, recycled carpets are becoming increasingly popular, providing a way to reduce waste without compromising on quality or aesthetics.

8. When Rugs and Carpets May Be a Bad Idea
There are situations where avoiding rugs and carpets might be the healthier choice:
- Households with Severe Allergies: Despite regular cleaning, the risk of allergen build-up may be too high.
- Homes with Poor Ventilation: Lack of proper airflow can exacerbate VOC emissions and moisture-related issues.
- High-Humidity Environments: Areas with excessive humidity are prone to mould growth in carpets.
9. Conclusion: Are Rugs and Carpets Truly Unhealthy?
The healthiness of rugs and carpets in your home depends on several factors, including the quality of the materials, maintenance practices, and the specific needs of your household. While they can pose risks such as allergen accumulation and VOC emissions, these concerns are manageable with proper care and informed choices.
For those who appreciate the comfort, warmth, and aesthetic appeal of rugs and carpets, the key is to balance their benefits with regular upkeep. By adopting a proactive approach to cleaning and selecting eco-friendly, low-VOC options, you can enjoy the charm of rugs and carpets without compromising your health.
Can rugs and carpets worsen asthma symptoms?
Yes, poorly maintained rugs and carpets can trap allergens and dust that exacerbate asthma symptoms. Regular cleaning and using hypo-allergenic materials can mitigate these risks.
Are wool rugs healthier than synthetic ones?
Wool rugs are generally healthier as they are natural, biodegradable, and less likely to emit VOCs. They also have hypo-allergenic properties.
How often should carpets be deep-cleaned?
It’s recommended to deep-clean carpets at least once a year. High-traffic areas may require more frequent cleaning.
Do carpets trap germs?
Yes, carpets can trap bacteria and germs, especially in areas where food is consumed. Regular vacuuming and deep cleaning are essential.
Are area rugs better for health than wall-to-wall carpeting?
Area rugs are easier to clean and replace, making them a healthier option for allergy sufferers compared to wall-to-wall carpeting.
Can using rugs reduce heating costs?
Yes, rugs can act as thermal insulators, helping retain heat in a room and reducing energy consumption during colder months. With the way Eskom is going, we need all the savings we can get.


